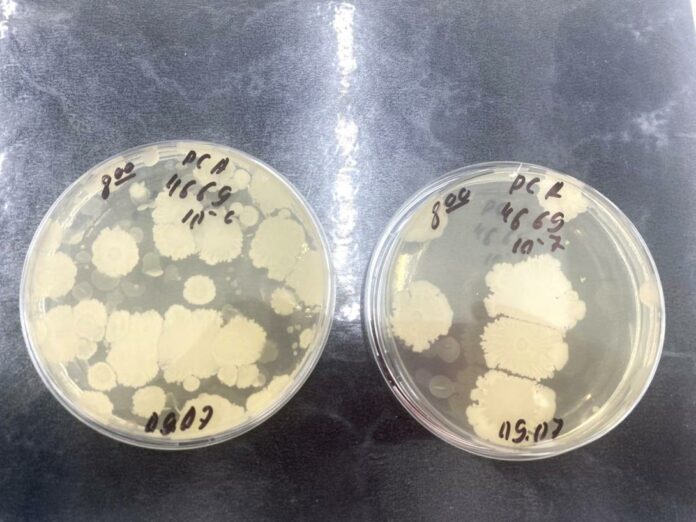

Picnicurile în aer liber și călătoriile cu mașina la distanțe mari sunt printre cele mai preferate activități ale moldovenilor în perioada estivală. Prepararea bucatelor în aer liber sau păstrarea produselor alimentare la temperaturi ridicate poate avea consecințe negative asupra calității și siguranței alimentelor.
Alimentele perisabile precum carnea, lactatele, ouăle sau salatele cu maioneză sunt cele mai vulnerabile la contaminare bacteriană. Chiar și o scurtă expunere la temperaturi ridicate poate favoriza înmulțirea bacteriilor precum E. Coli,Listeria monocytogenes , (pot provoca toxiinfecții alimentare grave).
În acest context, Agenția Națională pentru Siguranța Alimentelor (ANSA), de comun cu Laboratorul de încercări a produselor alimentare din cadrul IP Centrul Național Sănătatea Animalelor, Plantelor și Siguranța Alimentelor au realizat un experiment cu mai multe tipuri de produse alimentare perisabile, pentru a dovedi efectele temperaturilor ridicate asupra siguranței produselor alimentare, respectiv, asupra sănătății umane.
Au fost selectate produsele: mezel fiert, cașcaval, iaurt, ouă fierte și salată cu maioneză.

În rezultat:
- În proba de salată cu maioneză, în decursul a doar 4 ore, s-au dezvoltat Bacterii coliforme, iar în a doua zi și-au făcut apariția și bacterii de genul: E.coli.Tot din ziua întâi, s-a constatat dezvoltarea atât a drojdiile (au crescut cu peste 2 mii ori), cât și a mucegaiurile, care au crescut în mod exponențial. De asemenea, numărul total de colonii în salata cu maioneză a crescut de câteva zeci mii ori. Menționăm că, salatele au un termen de valabilitate foarte scurt, din cauza conținutului ridicat de apă și a ingredientelor perisabile (ouă, castraveți, tomate, ceapă, maioneză). La temperatura +10°C termen de valabilitate recomandat este de 2–4 ore maximum.
- Proba de ou fiert:faptul că oul fiert este considerat a fi stabil la temperaturi ridicare –este un mit. Chiar în a doua zi și-au făcut apariția bacteriile coliforme iar mirosul a devenit impropriu la sfârșitul primei zile.
- În proba de iaurt: din prima zi și-au făcut apariția drojdiile, iar în a doua zi – mucegaiurile.
- În proba de mezel (salam) –pe perioada de studiu, nu s-a depistat prezența bacteriilor coliforme, Escherichia Coli, dar din ziua 2 (12:00, t = 28ºC), s-a observat o evoluție de creștere a mucegaiului și a drojdiilor, peste 300 ori.
- În proba de cașcaval: conform datelor privind indicii organoleptici ai cașcavalului, pe perioada păstrării, în condiții fără regim termic optim, timp de 48 de ore, nu s-au atestat schimbări substanțiale privind aspectul și mirosul, dar conform rezultatelor microbiologice este evident că cașcavalul este supus unor schimbări nedorite, cum ar fi apariția mucegaiului, drojdiilor, ceea ce poate duce în eroare consumatorul și poate avea consecințe grave asupra sănătății.
IMPORTANT! Toate produsele au fost procurate din unitățile de comerț în ambalaj original de la producător, pentru a exclude contaminarea în timpul manipulării.
Modul de lucru: Produsele au fost porționate, în condiții sterile, a câte 14 eșantioane/fiecare produs și păstrate în recipiente sterile, în condiții fără regim termic optim, expuse la temperaturi de la 23-35°C (într-o geantă termoizolată) .
Investigații efectuate: produsele au fost analizate atât la indici microbiologici, cât și la cei fizico-chimici și organoleptici, în intervalele de ore 8:00, 12:00 și 16:00, în decursul de 48 de ore, de către Laboratorul de încercări a produselor alimentare din cadrul IP Centrul Național Sănătatea Animalelor, Plantelor și Siguranța Alimentelor,
Modificările organoleptice au fost sesizate în toate produsele din prime zi (cu excepția cașcavalului). Cu toate acestea, produsele au fost supuse unor schimbări microbiologice periculoase:
Este demonstrat că, prezența bacteriilor coliforme (și în special a E. coli) este un semnal de alarmă important privind calitatea sanitară a alimentelor, indicând un risc potențial de îmbolnăvire cu diverse patologii, de la o simplă diaree până la afecțiuni grave, care pot pune viața în pericol.
Drojdiile și mucegaiurile pot fi periculoase în alimente prin alterarea calității acestora, dar mai ales prin producția de toxine puternice (micotoxine) de către mucegaiuri, care pot avea efecte grave asupra sănătății umane pe termen scurt și lung.